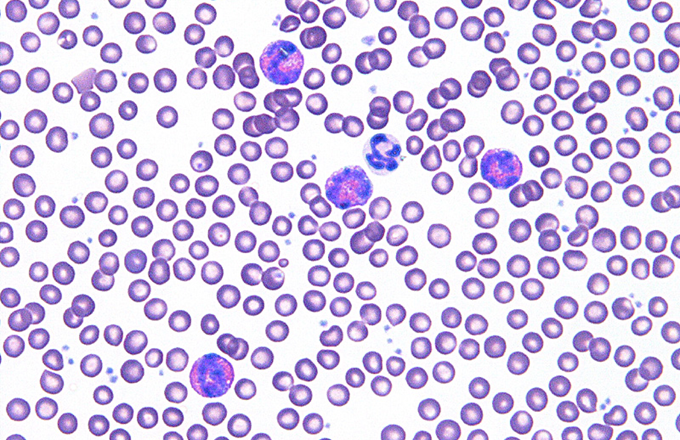

下痢
炎症性腸疾患(IBD:Inflammatory Bowel Disease)は腸管が炎症により慢性的な下痢や腹痛を起こし、人では主に潰瘍性大腸炎とクローン病を指しています。IBDはフェレットにおいても高い有病率を示す慢性炎症性疾患で、広範な臨床研究により、致死的な合併症に至る可能性があることが示されています 。フェレットIBDの臨床症状は非特異的ですが、最も一般的な主訴の一つは慢性または間欠性の下痢です 。IBDは、全身的な影響を及ぼし、体重減少、筋量低下、および栄養失調を伴うため 、積極的な管理が求められます。

炎症性腸疾患の定義と分類
IBDは、その名の通り臨床症状に基づく診断ではなく、消化管組織サンプル(胃および腸管)における炎症細胞の異常な蓄積によって組織学的に定義される症候群です 。この疾患の分類は、主に浸潤している炎症細胞の種類とその浸潤部位に依存します。フェレットのIBDは、組織学的な細胞浸潤パターンに基づき、大きく二つの主要なタイプに分類されます〔Lennox 2005〕。
リンパ球・形質細胞性胃腸炎 (Lymphoplasmacytic Enteritis, LPE): 最も一般的なIBDの形態であり 、腸管粘膜におけるリンパ球および形質細胞の蓄積を特徴とします。病理学者の間では、このパターンを指して一般に「炎症性腸疾患」と呼称することがあります。



好酸球性胃腸炎 (Eosinophilic Gastroenteritis, EGE): LPEと比較して稀な形態ですが、一般に重度な臨床経過を辿ることが知られています 。組織学的に中等度から多数の好酸球が胃腸管壁に浸潤している場合に、「好酸球性胃腸炎」という診断名が与えられます。特にEGEは若齢の雄で多く見られるという疫学的報告があり 、臨床徴候には、慢性または間欠性の下痢(粘液や新鮮血を伴うこともある)、嘔吐(重症例では噴出性のこともある)、体重減少、食欲不振、および元気消失などが含まれます 。身体検査では、腸管ループの触知可能な肥厚や、腹腔内リンパ節の腫大が認められることがあります 。病理学的な所見として、EGEにおける好酸球の浸潤は、粘膜層に限定されず、粘膜下層、筋層、さらには漿膜に至るまで、腸管壁の深部構造全体に及ぶことが顕微鏡画像で示されています 。このような広範囲にわたる浸潤が、重度の嘔吐や腸管の肥厚といった臨床症状の原因となります〔Hoefer et al.2014〕。


原因
IBDの正確な病因は「特発性」とされ、不明確なままですが 、何らかの要因が免疫システムを刺激し、消化管の内層を攻撃することで長期的な損傷を引き起こすというメカニズムが最も単純な説明とされています〔Lennox 2005〕 。
食事性抗原によるアレルギー説: 複数の獣医学的文献は、食事性アレルギーがIBDの最も一般的な誘因である可能性を指摘しています 。特に好酸球が優勢な炎症性浸潤のパターンは、食事性抗原に対する過敏反応(アレルギー反応)を示唆するものであり、EGEの病態においてこの説は非常に有力であると考えられています 。実際、難治性の症例の一部では、食事内容の変更によって臨床症状の改善が見られることが、この病因論を裏付けています〔Lennox 2005〕 。
Helicobacter mustelae感染症との関係性の再評価: フェレットの消化器疾患の議論において、Helicobacter mustelaeの存在は常に考慮されてきました。成獣フェレットは高い確率(100%)でこの細菌にコロニー形成され 、慢性的な胃炎を引き起こします。この胃炎は、近位十二指腸や前庭部で顕著であり、組織学的な病変は、ヒトのH. pyloriによる慢性活動性胃炎に類似します。しかし、近年の研究により、胃腸障害を持つ成人フェレットにおいて、外科的生検でH. mustelaeが認められることが稀であり、同菌がIBDや胃疾患の主要な原因ではないという認識が高まっています〔Pollock 2007〕。
診断・検査
フェレットIBDの臨床徴候(食欲不振、下痢、嘔吐、体重減少)は極めて非特異的であり、その診断を困難にしています 。これらの症状は、消化管リンパ腫 、伝染性カタル性腸炎(ECE)、異物 、およびアリューシャン病など、他の多くの重篤な疾患と重複します 。そのため、IBDの診断は、これらの鑑別診断候補、特に感染症や新生物を徹底的に除外した後に行われる除外診断となることが多いです。なお、血液検査ではEGEを患うフェレットの診断上、最も示唆的な所見の一つですが、末梢血の好酸球増多が認められないEGE症例も存在するため、好酸球増多の非存在はEGEを除外する根拠にはなりません 。
最終的には胃腸の外科的生検による病理組織学的検査で鑑別が行われます〔Lennox 2005〕。

治療
IBDの組織学的分類(LPEまたはEGE)は、単なる病理学的区別にとどまらず、その後の治療プロトコルと長期的な予後評価に決定的な影響を及ぼします。好酸球性炎症が優勢なEGEでは、食事性アレルギーの可能性が非常に高いため 、薬物療法に加え、加水分解食などの厳格な食事管理が優先されます 。 一方、LPEはリンパ球の増殖が顕著であるため、消化管リンパ腫への進行リスクが高いことが示唆されています 。このため、LPEと診断されたフェレットでは、食事管理よりも積極的な免疫抑制と、リンパ腫への厳重なモニタリングが臨床プロトコルにおいてより重要となります。このように、浸潤細胞の種類の特定は、獣医師が治療戦略を個別化するための直接的な指針となります。
基本的には免疫抑制剤としてコルチコステロイドが使用され、重篤であればアザチオプリンやシクロスポリも検討するべきです〔Johnson-Delaney 2006,Hoefer et al.2014〕。コルチコステロイドとしてプレドニゾンまたはプレドニゾロンは、炎症を抑制するための第一選択薬です 。これらは安価であり、フェレットにおいては短期間の使用であれば副作用が少ないとされています 。しかし、長期投与による副作用として、腹部膨満を伴う体重増加、皮膚の菲薄化、白内障、肝疾患などが観察されるため、定期的な肝酵素のチェックを含む血液生化学検査が推奨されます〔Lennox 2005〕。なお、ステロイドの投与は、フェレットに高頻度に見られるインスリノーマの管理を複雑化させます。アザチオプリンは プレドニゾンよりも副作用が少なく、良好な疾患コントロールをもたらす長期管理薬として有用性が示されています 。特に、IBDに伴う二次性肝炎(慢性リンパ球性門脈肝炎)を併発しているフェレットに推奨され、0.3 mg/kg q 24hまたは0.9 mg/kg q 48–72hの初期投与量が有効とされます〔Lennox 2005〕 。ただし、骨髄抑制などの副作用リスクがあるため、長期使用には慎重なモニタリングが必要です。シクロスポリンはステロイドやアザチオプリンに抵抗性を示す難治性IBD症例において、検討される免疫抑制剤です〔Cazzini P et al.2019,Lennox 2005〕。
IBDの病因における食事性アレルギーまたは不耐性の高い関与が示唆されることから 、長期的な食事管理は、単なる支持療法ではなく、根本的な治療戦略の一部として位置づけられます。特に好酸球性炎症が優勢なEGE症例においては、食事管理が薬物療法と同等かそれ以上に重要であると考えられます。 推奨される食事療法には、抗原性を最小限に抑えた製品や、穀物や豆類などのアレルゲンとなり得る成分を含まない高品質の肉食動物用製品への切り替えが含まれます。
管理と予後
フェレットのIBDは、特発性かつ慢性的な全身性疾患であり、多くの場合、生涯にわたる多角的な管理が必要です 。予後は、IBDの基礎的な原因、疾患の重症度、および免疫抑制療法や食事療法への反応によって大きく異なります。特に、IBDが進行し消化管リンパ腫へと移行した場合は、予後不良となります 。
今後の展望
フェレットIBDの病態生理にはまだ多くの不明点がありますが、Cazziniらによるフェレット特異的な組織学的グレーディングスキームの確立 は、臨床応用において客観性と一貫性をもたらし、予後評価と治療選択の精度向上に大きく貢献することが期待されています〔Cazzini et al.2020〕。
| 評価項目 | 病理学的所見 |
| 絨毛癒合の程度 | 消化吸収機能の慢性的な障害(吸収不良) |
| 出血および/またはフィブリン | 粘膜の重度の損傷、潰瘍または急性炎症の指標 |
| 上皮損傷 | 腸管バリア機能の破綻、二次感染リスクの増加 |
| 炎症密度の高さ | 炎症反応の活動度、治療反応性の予測 |
| 陰窩膿瘍の形成 | 破壊性炎症、または感染プロセスの存在 |
今後、この客観的評価基準に基づいた治療プロトコルの標準化が進むことで、より効果的で安全なフェレットIBD管理が実現されるでしょう。
参考文献
- Cazzini P et al.Proposed grading scheme for inflammatory bowel disease in ferrets and correlation with clinical signs.J Vet Diagn Invest30;32(1):17-24.2019
- Hoefer H,Bell J.Gastrointestinal diseases.In Quesenberry K,Carpenter J,eds.Ferrets, rabbits and rodents, clinical medicine and surgery.2nd ed.St.Louis.MO.Saunders.2014
- Johnson-Delaney CA. Anatomy and physiology of the gastrointestinal system of the ferret and selected exotic carnivores. In: Proc Annu Meet Assoc Ex Mammal Vet:29-38.2006
- Lennox AM.Gastrointestinal Diseases of the Ferret.Vet Clin North Am Exot Anim Pract7;8(2):213-225.2005
- Pollock C.Emergency Medicine of the Ferret.Vet Clin North Am Exot Anim Pract15;10(2):463-500.2007
